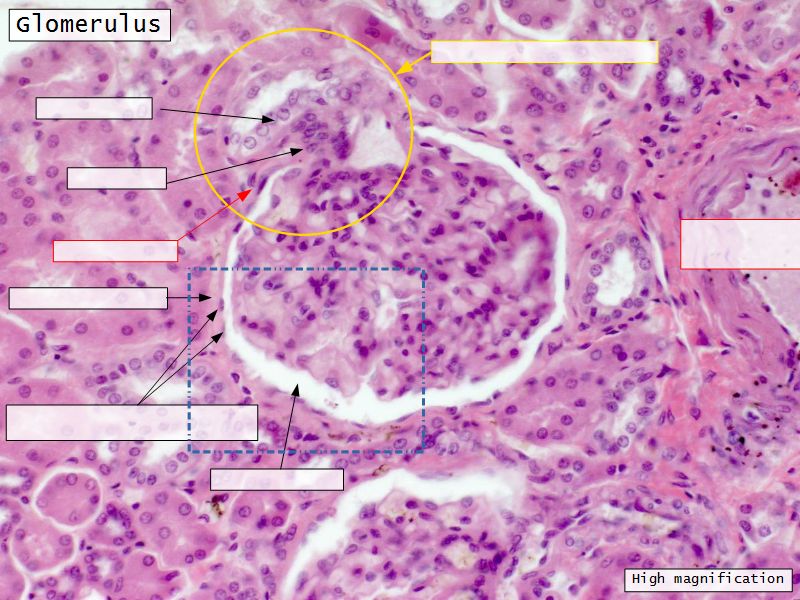
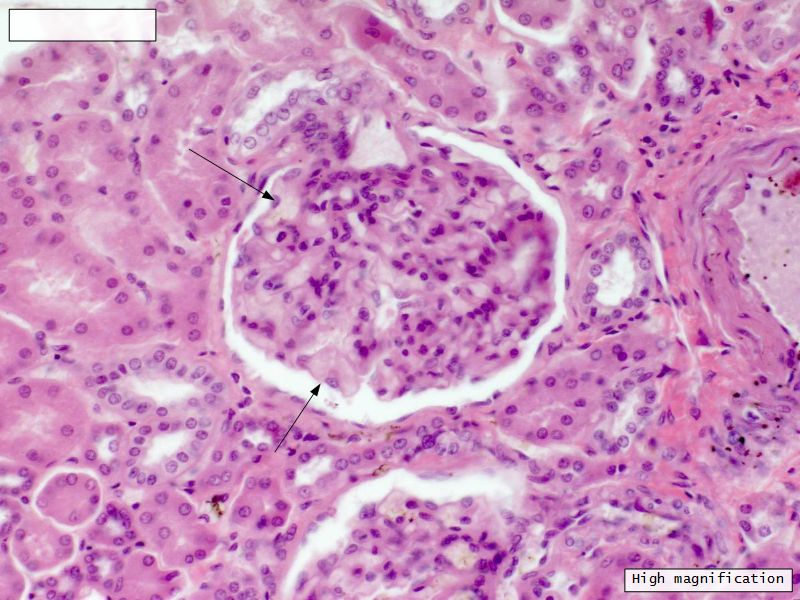
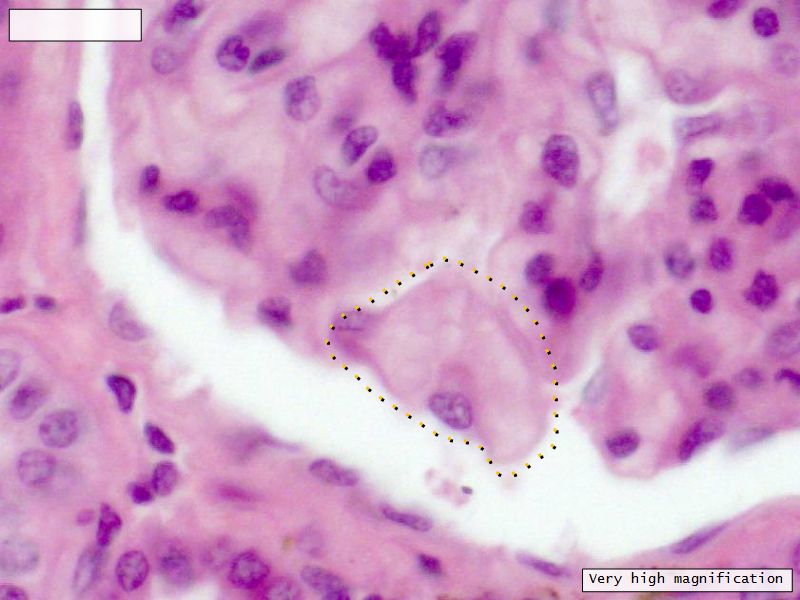
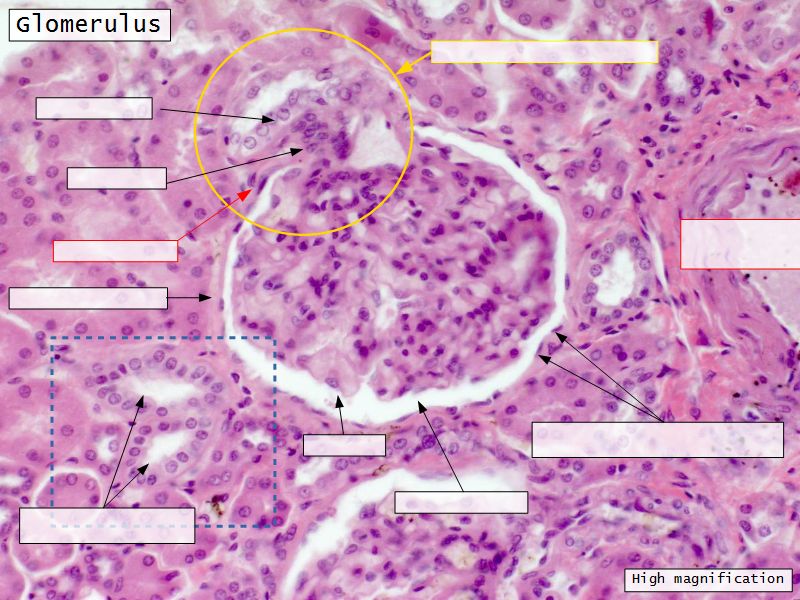
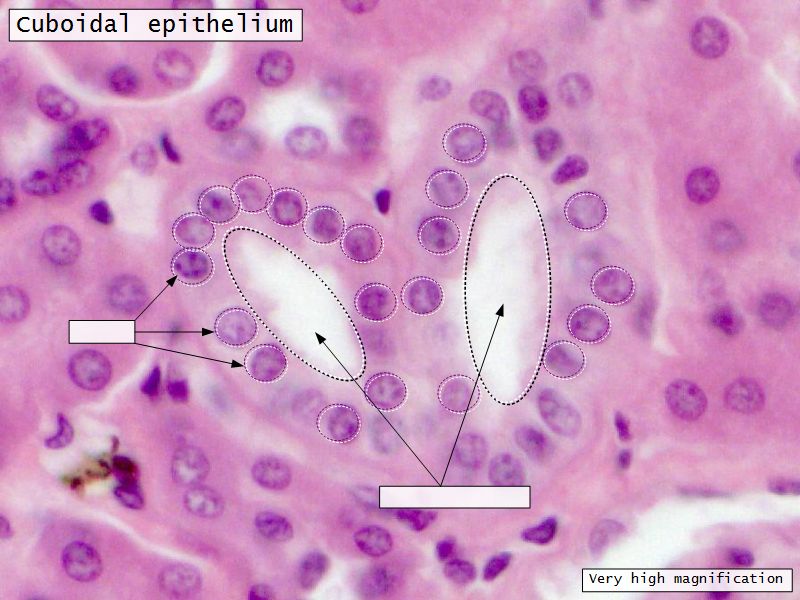

ADME
Metabolism - Kidney
Metabolism - Excretion - Urinary System - Kidney

- esc key shows all the slides
- arrows left right advance the slide
- mobile device swipe left right
- slides can go left-right and up-down
- ? gives instant help
- menu bottom left
- Have a pen & paper ready
- Fill in the blanks
- Answer every question
- Mark your answer after answering
- Elaborate on each answer
- Add relevant clinical content
- If you have trouble, ask


Organ
With which organ would you commonly associate cuboidal epithelium?Kidney
Slides 28 & 76





Kidney Objectives
- Basic anatomy of the kidney
- Basic arrangement of nephrons and collecting tubules in the kidney
- Structure of the nephron and collecting tubules
- The renal corpuscle
Kidney Tasks
- Make an annotated drawing of the macroscopic view of the kidney.
- Make an annotated diagram of a nephron, including the juxtaglomerular apparatus. Indicate the flow of blood and water in each part, and how solutes are filtered, secreted and reabsorbed.
- Complete the drawings for each slide in the practical workbook.
Kidney
- Capsule
- Cortex
- Medulla
- Multilobar
Multilobar
- Conical mass (pyramid)
- Medullary tissue
- capped with
- Cortex
- Delineated by
- Renal columns
- Apex of pyramid
- Papilla
- Projects into renal pelvis
Pyramid
- Simple columnar epithelium
- Continuous with transitional epithelium
Capsule
- Irregular dense CT
- Surrounded adipose tissue






Nephron
- Unit responsible for
- Filtration
- Excretion
- Resorption
- Include
- Kidney tubule
- Glomerulus
- Exclude
- Collecting tubule
Nephron
- Renal corpuscle
- Proximal convoluted segment
- Long loop of Henle
- Descending portion
- Ascending portion
- Distal convoluted segment




Appearance
- Cortex
- Renal corpuscles
- Convoluted tubules
- Medulla
- Loops of Henle
- Collecting tubules
Kidney lobule
- Group of neprons
- Open into branches
- Same collecting duct
- Not clearly demarcated
- Interlobular arteries/veins
Renal corpuscle
- Tuft of capillaries
- grow into
- Blind end of nephron
- Several layers of epithelium
- Two sides
- Vascular pole
- Tubular pole





























Blood flow
- Efferent arteriole
- Smooth muscle in media
- Capillaries
- Fenestrated
- Afferent arteriole
- Smooth muscle in media




Epithelium layers
- Capillary endothelium
- Visceral layer of epithelium
- Podocytes
- Resting on glomerular basement membrane
- Capsular space
- Parietal layer of epithelium
- Simple squamous epithelium




Glomerular filtration barrier
- Three layers
- Fenestrated epithelium
- Exclude blood cells & platelets
- Glomerular basement membrane
- Main filtration barrier
- Thick
- Fused epithelial & endothelial BM
- Replenished by podocytes due to removal by mesangial cells
- Glomerular epithelium
- Through filtration slit
Juxtaglomerular complex
Area where distal convoluted tubule return to glomerulus and pass through the notch between the afferent and efferent arterioles. Modification of the wall of the tubule and afferent arteriole and presence of specialised cells in the connective tissue.Modifications
- Distal convoluted tubule
- Macula densa
- Narrow epithelial cells
- Nuclei densely packed
- CT cells
- Laci cells
- Similar to mesangial cells
- Afferent arteriole
- Modified smooth muscle cells
- Juxtaglomerular cells
- Secretory function
Capillaries
- Supported by
- Mesangial cells
- Mesangial matrix
- Phagocytic
- Maintain basement membrane
- Remove macromolecular deposits
Mesangial cells
- Around capillary loops at vascular pole
- Phagocytic
- Maintain basement membrane
- Remove macromolecular deposits

Podocytes
- Visceral layer of epithelium
- Protrude into capsular space
- Attached to basement membrane
- Long cytoplasmic extensions
- Primary processes
- Secondary processes
- Podocyte feet
- Tightly spaced
- Filtration slits 20 - 30 nm wide

Proximal convoluted segment
- Longest part of nephron
- Wide triangular cell
- Spherical nucleus
- Indistinct cell borders
- Luminal surface
- Striated brush border
Long loop of Henle
- Descending portion
- Thick
- Thin
- Ascending portion
- Thin
- Thick
Loop of Henle - thin
- Narrow lumen
- Thin wall
- Squamous epithelium
- Looks like capillaries
Loop of Henle - thick
Continuation of descending and ascending tubuliDistal convoluted tubuli
- Joins collecting tubule
- Cuboidal epithelium
- Light stained
- Wide looking lumen
- Indistinct borders

Collecting tubule
- Cuboidal to columnar epithelium
- Distinct lateral borders






Main collecting ducts
- Wide lumen
- Pale staining columnar cells

The End
Save Document
- Click the link above
- Print to PDF
Works best using Google Chrome
Others Browser YMMV